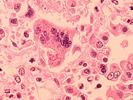

Eyder Peralta appears in the following:
WATCH: A Robot That Just Won't Quit Even When It's Kicked
Monday, February 09, 2015
We are fans of robots on this blog. (And we're not just saying that because sometimes we're afraid that they'll get too smart for our own good.)
We're saying it because we saw a video today that left us wowed.
Boston Dynamics, the Google-owned defense contractor that ...
Samsung's Privacy Policy Warns Customers Their Smart TVs Are Listening
Monday, February 09, 2015
A bit of fine print included in Samsung's privacy policy is drawing comparisons to George Orwell's 1984.
All of Samsung's smart TVs — which take voice commands — come with a warning to consumers that essentially says: Your TV is listening and might be sending what you say to ...
With New Rules In Place, Netflix Expands To Cuba
Monday, February 09, 2015
Taking advantage of new rules issued by the Obama administration, Netflix says it has expanded its service to Cuba.
In a press release, the company said any Cuban with an Internet connection and access to international payment methods would have access to a "curated" selection of movies and TV ...
University Of California System Will Require Measles Vaccine For New Students
Friday, February 06, 2015
The University of California system, with an enrollment of about 233,000, will require incoming students to be vaccinated for measles, mumps, rubella, chickenpox, meningococcus, tetanus and whooping cough beginning in 2017.
Currently, the university requires only that students be vaccinated against hepatitis B.
In a statement, the university said ...
British Tribunal Rules Mass Surveillance By Spy Agencies Was Illegal
Friday, February 06, 2015
A tribunal in London has ruled that the United Kingdom's mass surveillance of cellphone and online communications violated human rights.
NPR's Ari Shapiro reports that the government had already tweaked the program in response to concerns.
Ari filed this report for our Newscast unit:
"The Investigatory Powers Tribunal was ...
Army Will Award Fort Hood Victims Purple Hearts
Friday, February 06, 2015
The Army has decided to award the victims of the 2009 Fort Hood shooting with a Purple Heart, Texas Rep. John Carter said in a statement.
The issue has always been contentious, because the Army has always maintained the incident, in which Maj. Nidal Hasan, an Army psychiatrist, opened ...
ISIS Is Killing, Torturing, Using Children As Suicide Bombers, Says U.N. Report
Thursday, February 05, 2015
A United Nations committee that looks at the human rights of children around the world issued a startling report about how the Sunni extremist group that goes by Islamic State is treating children in Iraq.
In a report released on Wednesday, the U.N. Committee on the Rights of the Child ...
Mexican President Orders Investigation Into His Own Potential Conflict Of Interest
Tuesday, February 03, 2015
Mexican President Enrique Peña Nieto is asking a government watchdog agency to look into the purchase of homes by himself, his wife, and his finance minister from contractors who were then awarded lucrative construction projects by the government.
Critics have charged that the Peña Nieto government faced conflicts of interest ...
Conservative Neurosurgeon Ben Carson Says Vaccines Are A Must
Tuesday, February 03, 2015
Ben Carson, a world-renowned neurosurgeon and conservative who is considering a run for president, was unequivocal when it came to the issue of vaccines: It's a public safety issue and Americans should be required to vaccinate their children.
"When you have diseases that have demonstrably been shown to be curtailed ...
Arrest Warrant For Argentine President Found In Dead Prosecutor's Home
Tuesday, February 03, 2015
Alberto Nisman, the dead Argentine prosecutor who was investigating what he said was the cover-up of a deadly bombing at a Jewish center 20 years ago, had drafted an arrest warrant for the country's president, Cristina Fernandez.
The Argentine paper El Clarín made the bombshell allegation on Sunday, saying investigators ...
U.S. Walks Back Decision To Classify Info On Afghan Security Forces
Monday, February 02, 2015
The United States is walking away from a decision to classify detailed statistics about the Afghan security forces.
As we reported, the U.S. Special Inspector General for Afghan Reconstruction, or SIGAR, complained that the classification of this information — everything from numbers on equipment to training to attrition — ...
Super Bowl XLIX Was Most Watched Show In TV History
Monday, February 02, 2015
Super Bowl XLIX, a thrilling contest that came down to an unbelievable interception in the fourth quarter, has become the most watched show in television history.
According to numbers released by the ratings agency Nielsen, 114.4 million Americans tuned in to watch the Patriots beat the Seahawks 28 ...
WATCH: Groundhog In Wisconsin Bites Mayor's Ear
Monday, February 02, 2015
If you've had enough with winter and Punxsutawney Phil let you down (he saw his shadow) then another little marmot in a small town in Wisconsin has your ticket.
Apparently, Jimmy the Groundhog, of Sun Prairie, Wisconsin, doesn't play by the rules.
Video shows Mayor Jon Freund listening carefully ...
WATCH: Forget Crop Circles, This Farmer Is Making Art With His Cows
Friday, January 30, 2015
We'll get back to the news in no time, but first, a bit of mischief from a farmer in Kansas.
Derek Klingenberg put a drone over a field in his farm. He then used his tractor to drop some feed in strategic places. He uploaded the result to YouTube, this ...
After Testing Positive For EPO, Running Star Rita Jeptoo Banned For 2 Years
Friday, January 30, 2015
One of marathoning's brightest stars has been banned for two years, after testing positive for a performance-enhancing drug.
Athletics Kenya, the body that governs running in the country, said Rita Jeptoo tested positive for erythropoietin, or EPO, a popular performance-enhancing drug.
Jeptoo has won the Boston Marathon three times ...
As Deadline Passes, The Fate Of ISIS Hostages Is Uncertain
Friday, January 30, 2015
As a deadline came and went, the fate of two hostages being held by the Islamic State is uncertain.
As we've reported, Jordan has indicated it was willing to release a convicted terrorist in exchange for the release of a Jordanian prisoner. On Thursday, Jordan demanded proof of life ...
South Africa Grants Parole To Notorious Apartheid-Era Death Squad Leader
Friday, January 30, 2015
The South African government has decided to grant parole to a notorious Apartheid-era death squad leader.
As The Guardian reports, Eugene de Kock, who was known as "Prime Evil," was sentenced to two life terms in connection to the killings.
"South Africa's justice minister, ...
At Least 3 Dead, Dozens Injured In Explosion At Mexico City Maternity Hospital
Thursday, January 29, 2015
At least three people are dead, after a gas tank truck exploded near a maternity and children's hospital in Mexico City on Thursday.
Television images showed the explosion caused the collapse of a big part of the hospital, the gas truck still smoldering as fighters tried to quell the blaze.
...Jordan Demands Proof Of Life From ISIS Militants
Thursday, January 29, 2015
Jordan is asking the so-called Islamic State to prove that a pilot the group is holding is still alive.
Mohammed al-Momani, a spokesman for the Jordanian government, said the government is seeking proof of life before it releases Sajida al-Rishawi, an Iraqi woman who was convicted in relation to a ...
Raúl Castro Demands Return Of Guantánamo Before Normalizing Ties With U.S.
Thursday, January 29, 2015
Cuban President Raúl Castro seemed to throw some pretty big hurdles in front of efforts to establish normal diplomatic relations with the United States.
In a speech at a summit of Latin American countries, President Raúl Castro said a rapprochement with its northern neighbor would not make sense without three ...